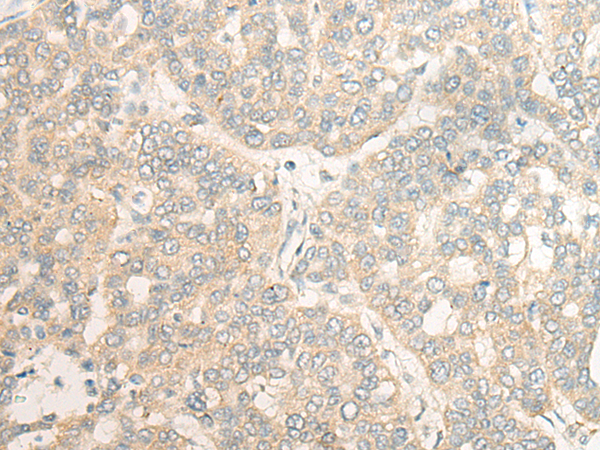

中文名稱:兔抗CPVL多克隆抗體
|
Background: |
The protein encoded by this gene is a carboxypeptidase and bears strong sequence similarity to serine carboxypeptidases. Carboxypeptidases are a large class of proteases that act to cleave a single amino acid from the carboxy termini of proteins or peptides. The exact function of this protein, however, has not been determined. At least two alternatively spliced transcripts which encode the same protein have been observed. |
|
Applications: |
ELISA, IHC |
|
Name of antibody: |
CPVL |
|
Immunogen: |
Fusion protein of human CPVL |
|
Full name: |
carboxypeptidase, vitellogenic like |
|
Synonyms: |
HVLP |
|
SwissProt: |
Q9H3G5 |
|
ELISA Recommended dilution: |
5000-10000 |
|
IHC positive control: |
Human liver cancer; |
|
IHC Recommend dilution: |
20-100 |
購(gòu)物車
購(gòu)物車 幫助
幫助
 021-54845833/15800441009
021-54845833/15800441009
